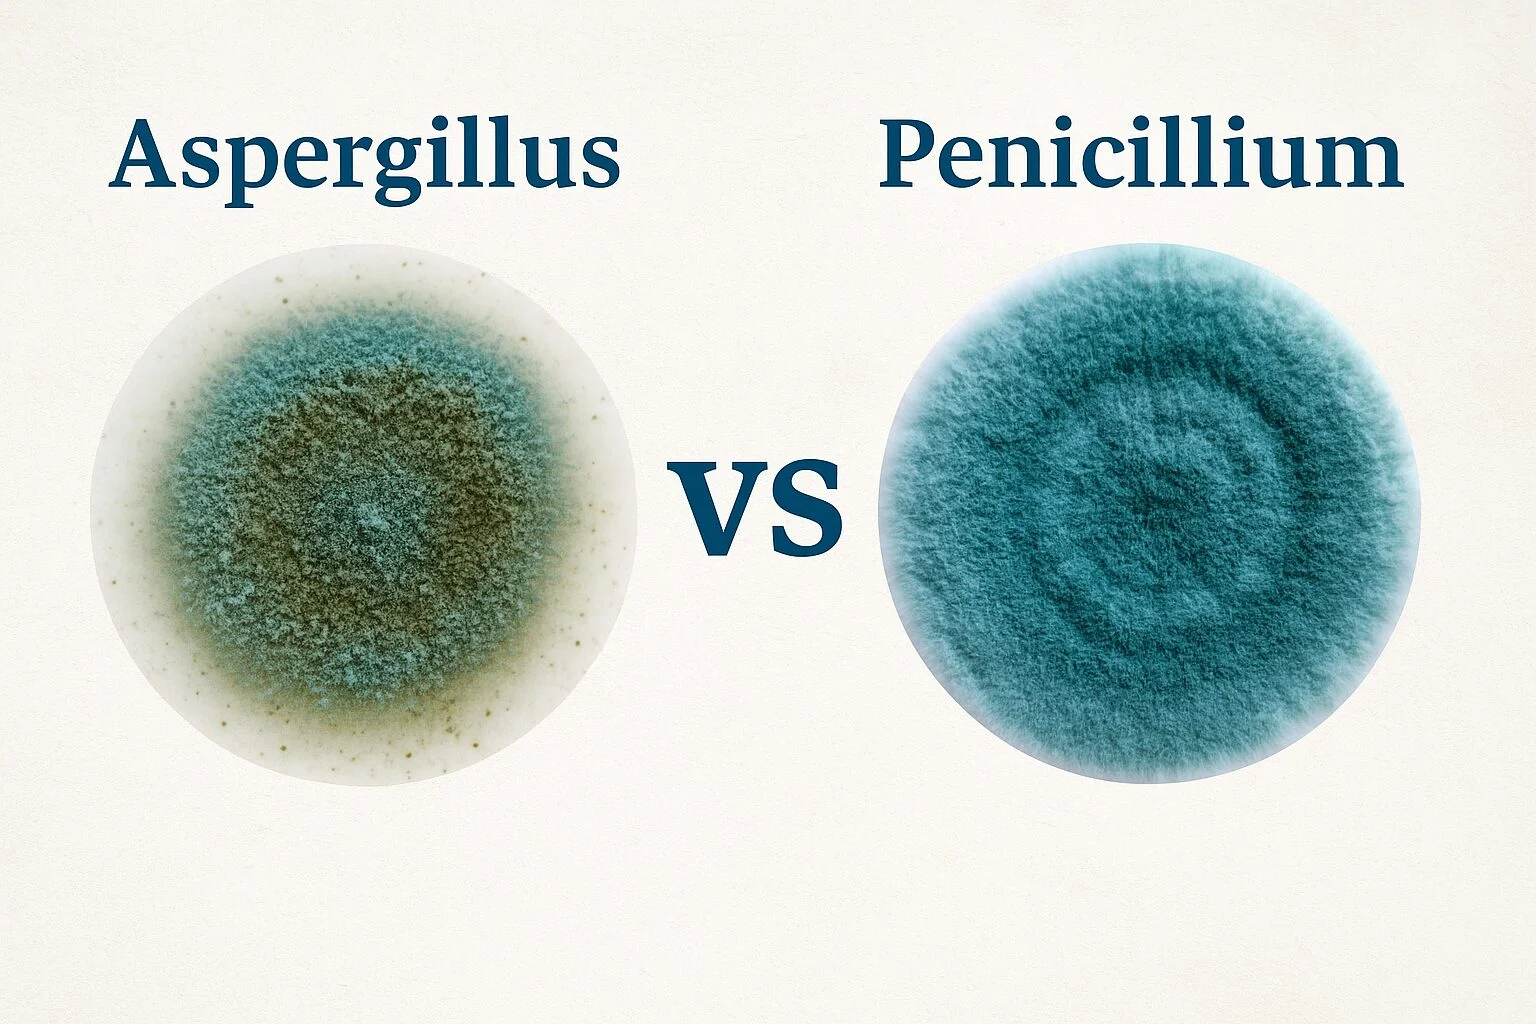
spergillus-vs-Penicillium-mold-comparison

Aspergillus vs Penicillium Mold: Everything You Need to Know
Among the most common indoor molds are Aspergillus and Penicillium, two types that thrive in damp conditions, HVAC systems, basements, and even on everyday household materials. While not every species…



















